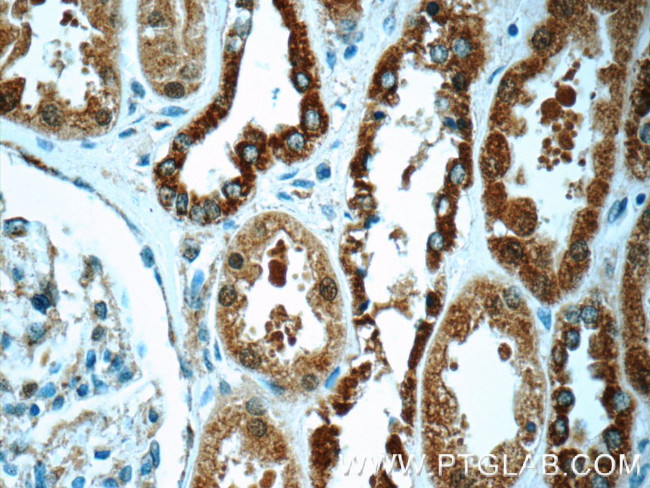
FAM20C Antibody in Immunohistochemistry (Paraffin) (IHC (P))

Search
Proteintech
FAM20C Polyclonal Antibody
{{$productOrderCtrl.translations['antibody.pdp.commerceCard.promotion.promotions']}}
{{$productOrderCtrl.translations['antibody.pdp.commerceCard.promotion.viewpromo']}}
{{$productOrderCtrl.translations['antibody.pdp.commerceCard.promotion.promocode']}}: {{promo.promoCode}} {{promo.promoTitle}} {{promo.promoDescription}}. {{$productOrderCtrl.translations['antibody.pdp.commerceCard.promotion.learnmore']}}
产品信息
25395-1-AP
种属反应
宿主/亚型
分类
类型
抗原
偶联物
形式
浓度
规格
纯化类型
保存液
内含物
保存条件
运输条件
产品详细信息
Immunogen sequence: AHRPLLRDP GPRRSESPPG PGGDASLLAR LFEHPLYRVA VPPLTEEDVL FNVNSDTRLS PKAAENPDWP HAGAEGAEFL SPGEAAVDSY PNWLKFHIGI NRYELYSRHN PAIEALLHDL SSQRITSVAM KSGGTQLKLI MTFQNYGQAL (121-269 aa encoded by BC040074)
靶标信息
Calcium-binding protein which may play a role in dentin mineralization.
仅用于科研。不用于诊断过程。未经明确授权不得转售。
生物信息学
蛋白别名: Dentin matrix protein 4; DMP-4; Extracellular serine/threonine protein kinase FAM20C; family with sequence similarity 20, member C; GEF-CK; Golgi casein kinase; Golgi-enriched fraction casein kinase
基因别名: C76981; DMP-4; DMP4; FAM20C; G-CK; GEF-CK; Kiaa4081; mKIAA4081; RGD1311980; RNS
UniProt ID: (Human) Q8IXL6, (Mouse) Q5MJS3
Entrez Gene ID: (Human) 56975, (Mouse) 80752, (Rat) 304334